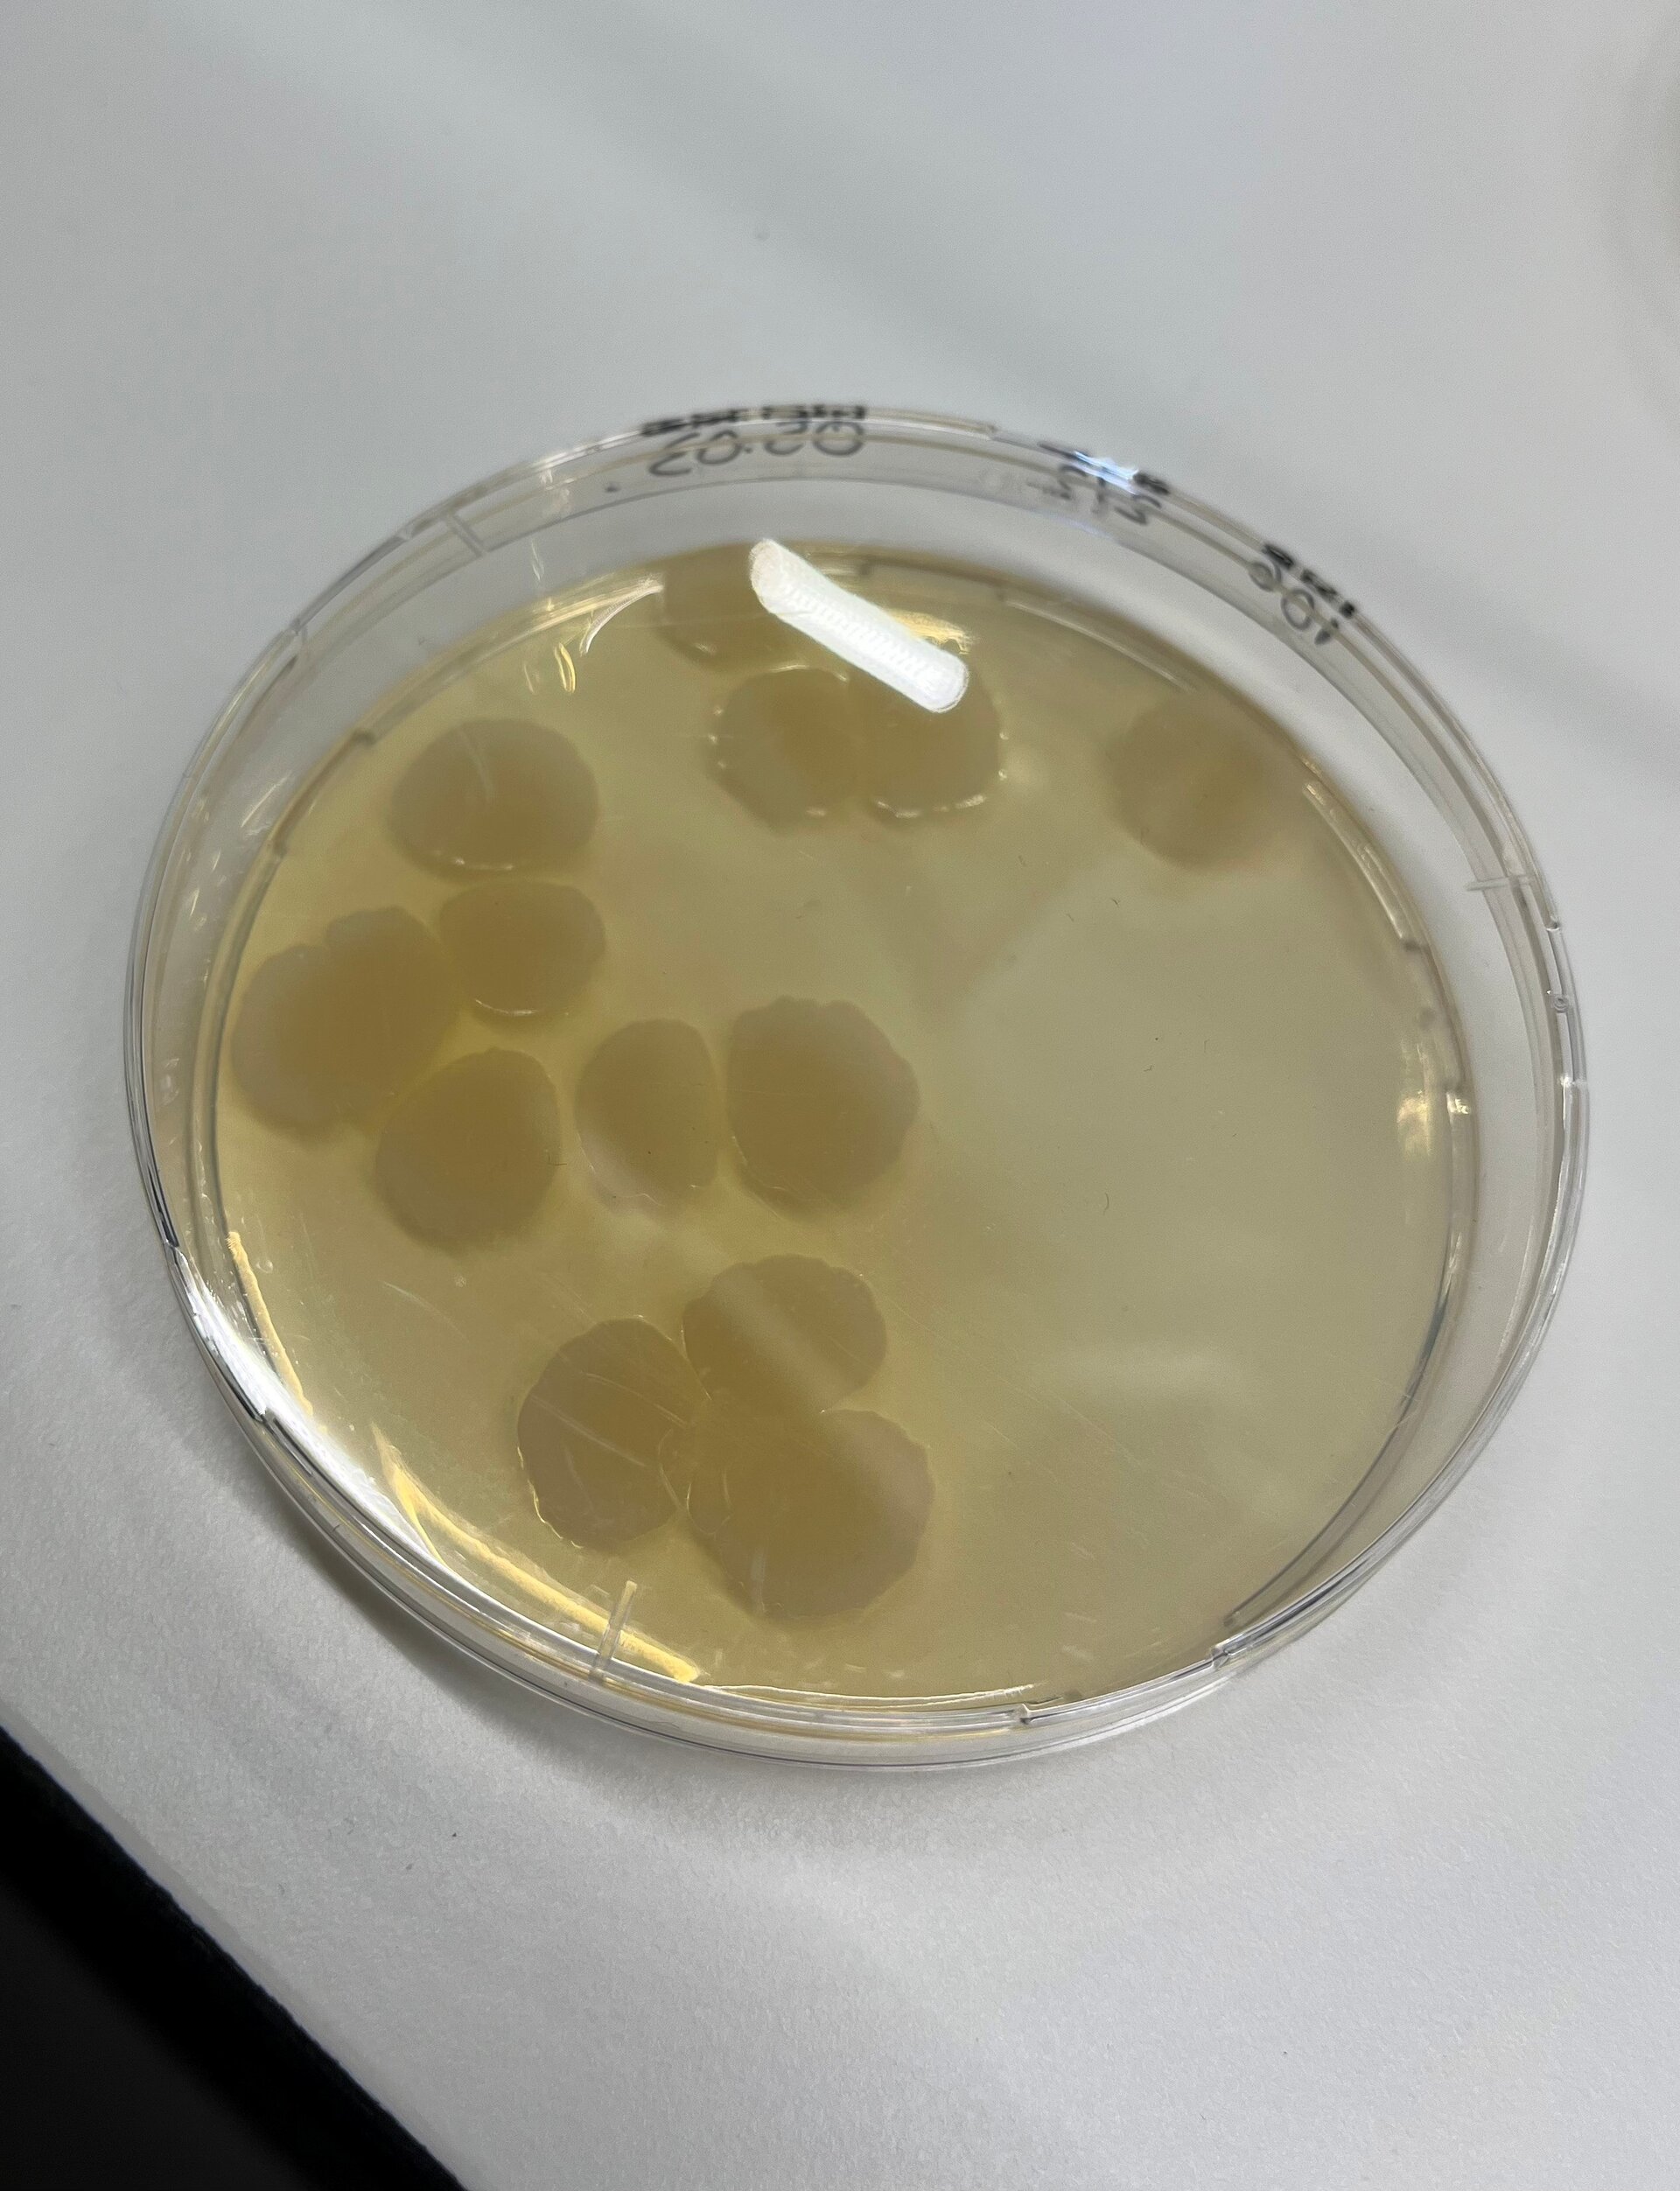

Syngenta. Der Innovations-Werkzeugkasten verändert sich
Seit 2019 sind in der EU 84 chemisch-synthetische Wirkstoffe weggefallen! Gleichzeitig gab es 2025 für mehr als 120 Pflanzenschutzmittel Notfallzulassungen – ein neuer Rekord. Das unterstreicht, wie groß die Lücken bereits heute sind. Und sie werden künftig noch größer! Hinzu kommt, dass neue Wirkstoffe oft jahrelang in den Mühlen der EU-Genehmigungsprozesse festhängen – mit ungewissem Ausgang.
Welche Antworten Syngenta auf diese Herausforderungen liefert, hat das Unternehmen auf seiner Frühjahrspressekonferenz im neuen „Seedcare & Biologicals Institute“ in Frankfurt/Höchst kundgetan.
Integrierte Lösungsansätze sollen neben dem klassischen Pflanzenschutz die Züchtung, Biologicals & Seedcare sowie die Präzisionslandwirtschaft liefern.
„In der Züchtung befinden wir uns an einem Wendepunkt,“ sagt Dr. Heike Köhler, Geschäftsführerin der Syngenta Seeds GmbH. „Neue Sorten müssen nicht nur hohe Erträge liefern, sondern auch Krankheiten, Trockenheit und den Wegfall von Pflanzenschutzmitteln kompensieren.“ Dafür setzt Syngenta konsequent auf moderne Züchtungsmethoden wie Predictive Breeding, molekulare Marker, den Einsatz von KI und genomische Selektion. Mit Hybridgerste ist das Unternehmen bereits seit einigen Jahren erfolgreich am Markt. Bei Weizen ist in Deutschland die Markteinführung von Hybriden für 2029 geplant.
Durch den drohenden Verlust des Schlüsselwirkstoffs Fludioxonil läuft auch im Bereich der Getreidebeizung die Suche nach Alternativen auf Hochtouren. Syngenta bereitet sich darauf vor und bietet mit Celest Next eine neue Prothioconazol-basierte Beize an, die bereits zugelassen ist. Parallel dazu wird die Forschung an biologischen Saatgutbehandlungen vorangetrieben. Die Kombination aus chemischen und biologischen Beizen soll künftig ein breiteres Wirkspektrum mit gleichzeitig besseren Umwelteigenschaften ermöglichen.
Digitale Technologien vervollständigen den integrierten Ansatz von Syngenta. Mit der „Cropwise-Plattform“ bietet das Unternehmen datengestützte Entscheidungshilfen an – von der satelliten- und drohnengestützten Feldüberwachung über KI-gestützte Prognosemodelle bis hin zur variablen, teilflächenspezifischen Applikationstechnik.